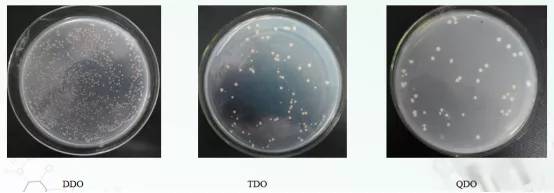
诱饵质粒重组质粒pgbkt7-a和猎物空载pgadt7共转化y2hgold酵母菌株

酵母菌平板

b:kanmx抗性基因剔除后菌株点接种于含有g418的yepd平板
图片尺寸1430x953
霉菌和酵母菌显色平板9cm(2-8℃) hbpm7010-1 9cm*10个/包
图片尺寸1000x1000
一株酿酒酵母及其在酿造菊花风味白酒中的应用方法技术
图片尺寸317x307
酵母cdna文库菌液在sd/-leu平板
图片尺寸1575x1088
检易霉菌酵母菌即用型平板 48小时计数 菌落无蔓延扩散#食 - 抖音
图片尺寸1080x1095
请问这初步判断是什么酵母,附上镜检和平板图-1
图片尺寸674x900
图为酵母菌实验装置.
图片尺寸3024x4032
玫瑰红纳琼脂平板 9cm10只/包 用于霉菌酵母菌计数 芜湖欧克生物
图片尺寸800x800
作双杂交酵母平板长出红色小菌落
图片尺寸614x461
请问这初步判断是什么酵母,附上镜检和平板图-4
图片尺寸675x900
有两个霉菌和酵母检测的平板,帮忙看怎么数
图片尺寸960x1280
酿酒酵母啤酒酵母酿酒干活型酵母
图片尺寸640x452
酵母浸出粉胨葡萄糖琼脂培养基(ypd)的应用
图片尺寸377x419
2ml 菌悬液 打入平板中
图片尺寸379x230
请问这初步判断是什么酵母,附上镜检和平板图-9
图片尺寸675x900
021010b 孟加拉红(虎红)琼脂平板 即用成品 90mm
图片尺寸750x375
诱饵质粒重组质粒pgbkt7-a和猎物空载pgadt7共转化y2hgold酵母菌株
图片尺寸554x193
请问这初步判断是什么酵母,附上镜检和平板图-15
图片尺寸603x806
请问这初步判断是什么酵母,附上镜检和平板图-6
图片尺寸900x673
求助用平板培养的真菌的图片
图片尺寸600x450